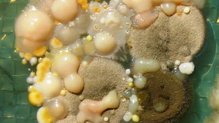
Mischkultur Schimmelpilzansammlung

Biologische Gefährdungen
Tätigkeiten mit Biostoffen (z. B. Bakterien, Viren, Schimmelpilzen) bergen Risiken wie Infektionen und Allergien für die Beschäftigten (siehe auch Biostoffverordnung). Ein umfassendes europäisches Normenpaket, speziell im Bereich Biotechnologie, hatte u. a. technische und organisatorische Maßnahmen zur Vermeidung dieser Risiken im Fokus. Die Produktnormung von Arbeitsmitteln wie z. B. Normen zu mikrobiologischen Sicherheitswerkbänken spielt hier eine wichtige Rolle. Auch sogenannte nicht-gezielte Tätigkeiten mit Biostoffen z. B. im Kompostierwerk oder im Arztlabor sind Thema der arbeitsschutzbezogenen Normung (z. B. durch die Entwicklung von Messverfahren zur Bestimmung bestimmter Biostoffe). Hilfreich in diesem Bereich ist auch die Biostoffdatenbank von DGUV, BG RCI und BMAS.
Die KAN-Geschäftsstelle hat sich auch mit der Normung von Infektionsschutzmasken beschäftigt. Auf europäischer Ebene wird eine neue Normenreihe für Masken mit Prüfverfahren für Eigen- und Fremdschutz vor luftübertragbaren Infektionen erarbeitet. Da die Infektionsschutzmasken auch zum Schutz von Beschäftigten eingesetzt werden könnten, ist das Normungsvorhaben für die Arbeitsschutzkreise von großem Interesse.
Dr. Anja Vomberg
vomberg@kan.de
KANBrief-Artikel zum Thema
- KANBrief 1/22 “Normung von Infektionsschutzmasken”
Datenbank informiert über Risiken von Biostoffen
Die Datenbank ist ein Kooperationsprojekt der DGUV, der BG RCI und des BMAS. Der Zugriff ist für alle kostenfrei und ohne Registrierung unter der Adresse http://www.dguv.de/ifa/gestis-biostoffe möglich.
Zu Pressemitteilungen der DGUV (pdf) und des BMAS

